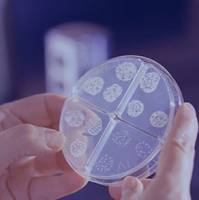
产品图

上海质方生物科技有限公司免费会员
公司介绍
上海质方生物科技有限公司是一家专注于细胞、细菌和病毒培养与销售的创新型生物科技企业。公司致力于为生命科学研究、诊断和工业应用提供高质量的生物材料,推动技术进步与产业升级。公司始终坚持以科技创新为驱动,借助现代化生产工艺和严格的质量管理体系,确保每一份产品都能满足高标准要求。
以科技创新为驱动,为客户提供安全、环保、高效的微生物产品和定制化技术解决方案,助力科研和产业应用的不断进步。 创新: 不断追求技术革新与产品升级 精准: 精益求精,确保每一项产品指标精准稳定 可靠: 严格把控质量,让客户放心使用 共赢: 携手合作,共同推动生物科技行业的发展
供应产品
详细信息
| 公司名称 | 上海质方生物科技有限公司 | 企业类型 | 民营 |
| 经营模式 | 企业地区 | 上海-奉贤区 | |
| 经营地址 | 上海市奉贤区楚华北路2258号2幢1层 | 主要产品 | |
| 公司成立时间 | 2024 | 公司网址 |
免责声明:以上所展示的信息由企业自行提供,内容的真实性、准确性和合法性由发布企业负责,丁香园对此不承担任何保证责任。